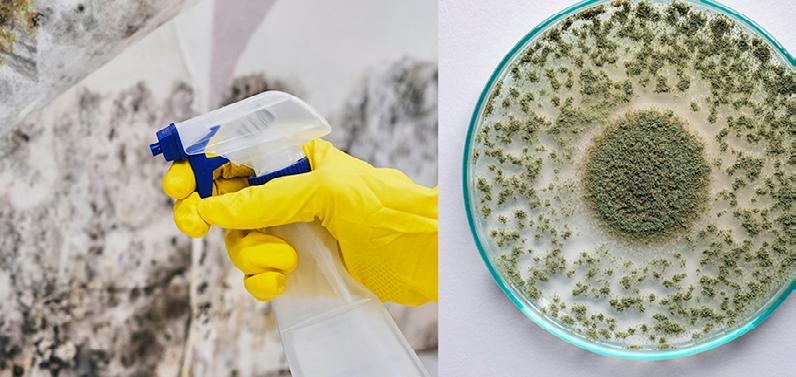

Katalog proizvoda
specijalizirano & profesionalno
mentorski
koloritno
brzo & lako
progresivno & tehnološki
Profesionalci, hobisti & perfekcionisti.
Ponuda vrijedi od 1.10. do 31.10.2025.
01 Hidroizolacija
Hidroizolacija je postupak zaštite građevina od prodora vode i vlage korištenjem posebnih materijala i metoda. Time se produžuje vijek trajanja konstrukcije, sprječavaju oštećenja i osiguravaju zdraviji uvjeti stanovanja.

Brzosušeća tekuća membrana, spremna za upotrebu, za hidroizolaciju vlažnih područja kao što su kupaonice, tuškabine, sušionice rublja, saune, balkoni i terase, prije polaganja završnih obloga.
Brzosušeća hidroizolacija spremna za upotrebu, 15 kg
Najniža cijena u 30 dana: 97,05 €/kom 97,05 €/kom



MAPELASTIC Zero A+B - 2K visokoelastični cementni mort
84,00 €/kom
Najniža cijena u 30 dana: 84,00 €/kom

WEBERTEC D-MAX 2K (A+B) elastična hidroizolacija 27 kg
41,57 €/kom
Najniža cijena u 30 dana: 41,58 €/kom
MAPEI Mapelastic TURBO A+B 20+16 kg cementni mort za hidroizolaciju terasa
155,25 €/kom
Najniža cijena u 30 dana: 165,60 €/kom

DRACO GARD 500 univerzalna poliuretanska hidroizolacija, 1 kg
12,42 €/kom
Najniža cijena u 30 dana: 14,61 €/kom


DRACO LASTIC 150 A+B fleksibilni polimer-cementni hidroizolacijski premaz, 20 kg
52,38 €/kom
Najniža cijena u 30 dana: 52,39€/kom

WEBERTEC D-PROTECT hidroizolacijski premaz koji štiti od prodora vode, 5 kg
17,00 €/kom
Najniža cijena u 30 dana: 18,00 €/kom



ZINSSER WATERTITE
HIDROIZOLACIJSKA BOJA ZA VLAŽNE ZIDOVE BIJELA, 5 L
Low-odour, acrylic, waterproofing paint
Sustav premaza u dva sloja. Prvi sloj premazuje i brtvi površinu. Drugi sloj dovršava procesbrtvljenja kako bi se osigurala zaštita od prodora vode i zaštita osušenog sloja od razgradnje gljivicama.
99,80 €/kom
Stops up to 2,5 bar water pressure (twice the strength of latex waterproofers) - less odour than latex paint
Najniža cijena u 30 dana: 124,75 €/kom
Prevents water-seepage through cement, masonry and concrete block walls and basement floor
Protection of the dried coat against fungal degradation
Can be applied to wet or dry surfaces
HIDROIZOLACIJA


LEAKSEAL
fleksibilni gumeni vodonepropusni premaz u spreju, 500 ml
15,10 €/kom

FILLCOAT FIBRES
vodonepropusni premaz s vlaknima
20,70 €/kom

FILLCOAT WATERPROOFING vodonepropusni premaz
25,10 €/kom
Najniža cijena u 30 dana: 25,88 €/kom
Najniža cijena u 30 dana: 18,88 €/kom
Najniža cijena u 30 dana: 31,38 €/kom



KATRAN BITUVAL AL4
parna brana, 10m2
Bitumenska traka primjenjuje se u jednoslojnom ili višeslojnom sustavu, ispod toplinsko-izolacijskog sloja, u funkciji parne brane. Primjenjuje se u sustavima nadzemnih hidroizolacija.



KATRAN VOALPLAST V-3
ljepenka sa staklenim valom v3 , 10m2
Bitumenska traka primjenjuje se u višeslojnom sustavu ispod gornjeg završnog izolacijskog sloja ili sloja mehaničke zaštite. Služi i kao prva traka za zaštitu toplinske izolacije. Primjenjuje se u nadzemnim sustavima izolacije.


KATRAN VOALPLAST V-4
ljepenka sa staklenim valom v4 , 10m2
Bitumenska traka primjenjuje se u višeslojnom sustavu ispod gornjeg završnogizolacijskog sloja ili sloja mehaničke zaštite. Služi i kao prva traka za zaštitu toplinske izolacije. Primjenjuje se u nadzemnim sustavima izolacije.
02 Fasadni sustavi
Pametna investicija za manju potrošnju energije.
Birajte pouzdanost, kvalitetu i sigurnost da će vaša fasada biti estetski privlačna i dugotrajna.



JUBIZOL EPS FASADNI SUSTAV
SUSTAV PO MJERI NA TOPLINSKOJ
IZOLACIJI OD POLISTIRENA
Izbor komponenti po mjeri s najboljim omjerom cijene i kvalitete
Široki izbor nijansi u zaglađenim i zaribanim strukturama
Dugotrajna otpornost na alge i plijesni
Dugotrajna postojanost nijanse
Jednostavan za ugradnju

JUBIZOL Unixil finish tankoslojna završna žbuka, savršena za postizanje intenzivnih i zasićenih boja

JUBIZOL Silicone finish za vrhunsku i dugotrajnu dekorativnu zaštitu fasadne površine







JUBIZOL GRAPHIT FASADNI SUSTAV
CarbonStrong finish
Završna žbuka sa mikro vlaknima
20% niža potrošnja materijala pri ugradnji + +
LIGHT & EASY tehnologija sa bazaltnim i karbonskim Fleksibilnost

EPS F-G0
Grafitna izolacijska ploča
20% bolja izolacija i tanje ploče +






FASADNI SUSTAVI
DALMATINER PREMIUM CARBON FASADA
OTPORNA NA TUČU
Odabir tamnih tonova do svjetlosne granice 10
Izvrsna otpornost na vremenske uvjete
Dugi vijek trajanja bez neugodnih pojava algi i gljivica
Fasada koja podnosi velika mehanička opterećenja
Odlična izolacija i otpornost na atmosferske utjecaje
Izvanredna vodoodbojnost i paropropusnost
Fasada koja se sama održava čistom



CAPAROL BASIC LINE FASADNI SUSTAV
Klasični fasadni sustav s izolacijom od stiropora
Ispunjava sve zahtjeve izolacije fasadne ovojnice u ekonomskom i tehničkom smislu
Visokokvalitetan sustav po pristupačnoj cijeni
Veliki izbor postojanih nijansi završne žbuke
Odlična otpornost na vremenske utjecaj




FASADNI SUSTAVI


TERMO FASADNI
SUSTAV S BIJELIM EPS-om:

ETA certificirani fasadni sustav
Jednostavna i brza izrada
Nepropustan
Optimalna izdržljivost nijansi boja
Dugoročno pouzdan i provjeren
Bez ograničenja u nijansama boja
Klasa reakcije na požar: B-s2-d0
TERMO FASADNI SUSTAV
S GRAFITNIM EPS-om:


Uz kvalitetan završni slojnajbolja vrijednost za vaš novac te maksimalna trajnost i zaštita vašeg objekta

ETA certificirani fasadni sustav
Lako nanošenje
Postojanost boje
Termoizolacijske značajke
Vodoodbojno
FASADNI
SUSTAVI

ROFIX AEROGEL FIXIT 244
učinkovita izolacija
svemirskom
tehnologijom

ŠTO JE AEROGEL?
Aerogel se prvotno primjenjivao u
svemirskoj tehnologiji - za izolaciju
svemirskih odijela kao i medij za pohranu plinovitih goriva. Aerogel se 90 do 98% sastoji iz zraka.

Vodoodbojnost – zaštita od kiše i vlage
Vrlo učinkovita toplinska izolacija
Ušteda prostora Paropropusnost –zidovi “dišu”







*Za otoke se dostava naplaćuje prema posebnom obračunu.
TON KARTA
FASADNI
SUSTAVI
03 Sustavi protiv plijesni
Plijesan i hladni mostovi? Ne čekaj da bude kasno – evo kako ih uspješno sanirati i trajno spriječiti.


Draco Clean 600
tekućina za čišćenje i odstranjivanje gljivica, plijesni i algi, 1 L
11,97 €/kom
Najniža cijena u 30 dana: 14,08 €/kom
Najčešće se plijesan pojavljuje na mjestima gdje je cirkulacija zraka slaba – u kutovima prostorija, iza ormara i kuhinjskih elemenata, oko prozora ili na vanjskim zidovima. Na tim točkama zrak “stoji”, a zidovi su često hladniji, što stvara savršenu podlogu za razvoj gljivica.
Jedan od glavnih uzroka su hladni mostovi – dijelovi konstrukcije kroz koje toplina brže “bježi” nego kroz ostatak zida. Takvi dijelovi brže se hlade, a kad na njih naiđe topli i vlažni zrak iz prostorije, dolazi do kondenzacije.
Tu dolazimo do drugog problema – visoke vlažnosti i loše ventilacije. Kada u prostoriji vlaga iz kuhanja, tuširanja ili čak disanja nema kamo otići, ona ostaje u zraku. Bez redovite izmjene zraka, ta vlaga se taloži na najhladnijim površinama. Na kraju, tu je i kondenzacija – prirodan proces koji se događa kada topli, vlažni zrak dotakne hladan zid. Na tim mjestima stvara se tanak sloj vlage, a upravo takvo okruženje idealno je za rast plijesni.
Ukratko, plijesan je rezultat kombinacije građevinskih nedostataka, previše vlage i nedovoljne ventilacije. A iako se ponekad čini kao “samo” vizualni problem, njezina prisutnost može dugoročno utjecati na zdravlje i trajnost vašeg doma.




Korak 1
Uklonite plijesan i dezinficirajte
Mehanički očistite površinu (četka, krpa, spužva), zatim obavezno nanesite sredstvo protiv plijesni ili otopinu alkohola/klora kako bi se spriječio brzi povratak.
Korak 2
Zaštitite zid bojom protiv plijesni
Na suhu, očišćenu površinu nanesite posebnu boju s fungicidnim i antibakterijskim svojstvima koja stvaraju barijeru protiv vlage i produžuju trajnost sanacije.
Korak 3
Uklonite uzrok
Izolirajte hladne mostove i smanjite vlagu provjetravanjem, odvlaživačima ili boljom ventilacijom kako bi se spriječilo ponovno stvaranje plijesni.


Algicid plus sprej 0,5 L
8,82 €/kom
Najniža cijena u 30 dana: 8,80 €/kom

Jubolin Thermo
5 L, unutarnja masa za izravnavanje s toplinskim svojstvima
19,43 €/kom
Najniža cijena u 30 dana: 22,86 €/kom
Caparol Indeko-W unutarnja boja protiv plijesni, algi i gljivica, 12,5 L
96,58 €/kom
Najniža cijena u 30 dana: 96,58 €/kom

Algicid Plus koncetrat sredstvo za uništavanje zidnih algi i plijesni, 0,5 L
7,64 €/kom
Najniža cijena u 30 dana: 7,64 €/kom


Ecotherm Primer rastvor akrilnog veziva s aditivima, 1 L
7,40 €/kom
Najniža cijena u 30 dana: 7,40 €/kom


Jupol Thermo toplinsko izolacijska unutarnja boja 5 L, bijela
40,47 €/kom
Najniža cijena u 30 dana: 40,48 €/kom


Ecotherm Premaz za toplinsku izolaciju unutrašnjih zidova, 10 L
167,55 €/kom
Najniža cijena u 30 dana: 167,55 €/kom


PUFAS TIEFENGRUND LF
akrilna dubinska impregnacija 1 L
5,97 €/kom
Najniža cijena u 30 dana: 7,03 €/kom


PUFAS PUFATHERM izolir ploče 500 x 1000
3,74 €/kom
Najniža cijena u 30 dana: 4,40 €/kom

PUFAS ljepilo za vlies tapete
240 g
4,48 €/kom
Najniža cijena u 30 dana: 5,28 €/kom

PUFAS ljepilo za stiropor 1 kg
4,48 €/kom
Najniža cijena u 30 dana: 5,28 €/kom
Caparol Capatox 1L
5,61 €/kom
Najniža cijena u 30 dana: 4,71 €/kom

PUFAS VLIES TRAKA
1 m x 25 m - traka za saniranje oštećenih i neravnih zidova
1,53 €/kom
Najniža cijena u 30 dana: 1,80 €/kom


Draco Shield 600
termo premaz protiv kondenzacije, gljivica i plijesni, 1 L
9,35 €/kom
Najniža cijena u 30 dana: 9,35 €/kom

INJEKTIRANJE
(lat. iniectare, iterativ od inicere: uvesti unutra)
ubrizgavanje je tekućih
ili žitkih sredstava u šupljine i pore tla ili
građevine radi postizanja vodonepropusnosti, učvršćivanja, konsolidacije ili homogenizacije.
Postupak se primjenjuje pri iskopu građevne jame.
Za injektiranje se najčešće koristi cementni mort ili
druge smjese cementa, gline, kemijskih sredstava, bitumenskih i drugih emulzija.
Za sprječavanje prodiranja vode ispod temelja kuće izvodi se injekcijska zavjesa. To je niz bušotina u koje se injektira sredstvo koje pod tlakom prodire u šupljine u tlu.



Sikamur Injectocream 100
masa za injektiranje za prekid kapilarne vlage, 560 ml
29,84 €/kom
Najniža cijena u 30 dana: 37,29 €/kom
Stigosil sredstvo za prekid toka kapilarne vlage, 10 L
35,52 €/kom
Najniža cijena u 30 dana: 44,40 €/kom

Antisol sanacijski premaz protiv isoljavanja, 5 L
16,24 €/kom
Najniža cijena u 30 dana: 20,29 €/kom
04 Blokatori mrlja
Specijalni premazi koji sprječavaju da tvrdokorne mrlje poput nikotina, vlage, čađe ili olovke probiju kroz novu boju ili žbuku. Nanose se prije završnog sloja boje kako bi površina ostala čista i jednolična.
COVERS UP blokator mrlja na stropu bijeli, 400 ml
8,93 €/kom


COVERS UP je akrilni temeljni premaz za blokiranje mrlja na bazi otapala i stropna boja u jednom.
ZINSSER
Najniža cijena u 30 dana: 11,16 €/kom



ZINSSER BULLS EYE 1-2-3
temeljni premaz i brtvilo na bazi vode , 1 L
19,23 €/kom
Najniža cijena u 30 dana: 24,04 €/kom
JUPOL BLOCK
Odlično prekriva i blokira problematične mrlje nikotina, katrana, požara, prljavštine, tanina i drugih bojila, vina, sokova, kave, vodenih boja, ulja, itd.
JUPOL BLOCK specijalna boja za blokadu mrlja, 5 L, bijela
60,70 €/kom
Najniža cijena u 30 dana: 75,88 €/kom


ZINSSER B-I-N
temeljni premaz i izolator mrlja, bijeli, 1 L
31,56 €/kom
Najniža cijena u 30 dana: 39,45 €/kom

ZINSSER B-I-N AQUA
temeljni premaz na bazi vode i izolator mrlja, 1 L
35,59 €/kom
Najniža cijena u 30 dana: 44,49 €/kom
CAPAROL
Aquasperrgrund fein
Za premaze sa dobrim izolacijskim svojstvima kad na podlogama postoje mrlje od nikotina, čađe i vode, sastojci koji puštaju boju i tvari koje sadrže anilin.

CAPAROL
Aquasperrgrund fein
izolirajući temeljni premaz, 12,5 L
174,76 €/kom
Najniža cijena u 30 dana: 218,45 €/kom


CAPAROL IsoDeck
Specijalna unutarnja boja za brzo i po okoliš neškodljivo renoviranje zidnih i stropnih površina zaprljanih nikotinom.

CAPAROL IsoDeck
specijalna antinikotinska boja, 12,5 L
88,47 €/kom
Najniža cijena u 30 dana: 110,59 €/kom
05 Industrijski premazi
Specijalizirani premazi za metal, beton i industrijske površine – formulirani za visoku otpornost, trajnost i zaštitu u zahtjevnim uvjetima. Kvaliteta koju prepoznaju profesionalci – pouzdano rješenje za dugotrajan i učinkovit rezultat.



PREPORUČENI SUSTAVI PREMAZA ZA
UNUTARNJE CEMENTNE
POVRŠINE POPUT PODOVA ILI ZIDOVA
PROZIRNI SUSTAV (NA BAZI OTAPALA)
Anchor-Fix 8231 SET** 2K epoksi impregnacijski premaz na bazi otapala prozirni
Acrifloor 8240 2K SET** akril-poliuretanski završni premaz na bazi otapala prozirni

VEĆ OD 4,29 €/m2*
Anchor-Fix 8231 SET** 2K epoksi premaz (impregnacija) na bazi otapala prozirni
NIJANSIRANI SUSTAV (NA BAZI OTAPALA) VEĆ OD 10,99 €/m2*
Resinkim 0436 SET** epoksi podni premazi na bazi otapala nijansirani
Acrifloor 8240 2K SET** akril-poliuretanski završni premaz na bazi otapala prozirni
NIJANSIRANI SUSTAV (NA BAZI VODE)
Aquafixer 8200 SET** 2K epoksi impregnacijski premaz na bazi vode prozirni
Aquaflox 2184 SET** 2K epoksi podni premazi na bazi vode nijansirani
Aquafloor 8210 SET** 2K akril-poliuretanski završni premaz na bazi vode
PREPORUČENI SUSTAVI PREMAZA ZA VANJSKE CEMENTNE POVRŠINE POPUT PODOVA ILI ZIDOVA
OD 16,39 €/m2*
NIJANSIRANI SUSTAV (NA BAZI OTAPALA) VEĆ OD 6,61 €/m2*
Anchor-Fix 8231 SET** 2K epoksi premaz (impregnacija) na bazi otapala prozirni
Acryver 1779 SET** 2K akril-poliuretanski završni prema na bazi otapala nijansirani
BOJA ZA SPORTSKE TERENE, BICIKLISTIČKE I PJEŠAČKE STAZE NA BETONU ILI ASFALTU VEĆ OD 2,99 €/m2*
Matchpoint 0294 1K akrilna boja na bazi vode
*izražena cijena je izračun teoretskog utroška boje za preporučenu debljinu premaza navedenu u tehničkom listu proizvoda za nijansu RAL 7040
**set proizvoda sastoji se od baze i odgovarajućeg katalizatora

06 Dekorativne tehnike
Više od boje – struktura, refleksija i dojam. Od industrijskog betona do elegantnog sjaja metala, otkrijte tehnike koje transformiraju zidove u element dizajna i naglašavaju osobnost svakog prostora.



PAILLETT 10, STAR boja sa svjetlucavim efektom, 2 L
Najniža cijena u 30 dana: 44,99 €/kom 35,99 €/kom
Akrilna ultra-mat puderasta brzosušiva visokoprekrivna boja na bazi vode.



CHARME
br. 1 LIN, 500 ml
Najniža cijena u 30 dana: 21,94 €/kom
17,55 €/kom



Metalizirajuća boja za zidove, zidne pločice i namještaj u interijerima.



Najniža cijena u 30 dana: 60,03 €/kom
Dizajnerska boja sa reljefnim efektom finog pijeska i pročistać zraka u prostoriji.



SABLE D’ETE
boja s efektom finog pijeska, 2 L
52,02 €/kom
Najniža cijena u 30 dana: 65,03 €/kom
Bezbojne kuglice za efekt pijeska na zidu.



PERLE DE VERRE bezbojna boja, 1 L
31,98 €/kom
Najniža cijena u 30 dana: 31,98 €/kom


Mineralni bijeli
temeljni
pastozni premaz za interijere na bazi vode. DEKORATIVNE

TEMELJ I NIVELIR MASA ZA ZIDNE PLOČICE
temeljni premaz za interijere, 1 L
23,97 €/kom
Najniža cijena u 30 dana: 29,96 €/kom


Temelj zidni premaz za boje
2,5 L
Najniža cijena u 30 dana: 35,99 €/kom
35,99 €/kom
Bezbojne sitne
kuglice za efekt pijeska na zidu.



PERLE DE SOIE
bezbojna boja, 200 ml
14,35 €/kom
Najniža cijena u 30 dana: 14,35 €/kom
Univerzalni prajmer za gotovo sve vrste podloga prije nanošenja završnih vodenih, akrilnih, poliuretanskih na bazi vode, alkidnih i uljanih završnih boja i premaza.

500

16,75 €/kom
TEMELJ ZA SPECIJALNE PODLOGE
ml
Najniža cijena u 30 dana: 20,94 €/kom
Zaštitni premaz za ‘id Loft Beton Original’, primjenjiv je na podu, u tuš prostoru i na pultovima. Otporan na habanje i neupojan kod prskanja vodom.


LOFT ZAŠTITA POD / TUŠ / PULT otporan zaštitni premaz, 1 L
56,03 €/kom
Najniža cijena u 30 dana: 70,04 €/kom
Sve za zid –od temelja do završne boje

1
NIVELIN
Disperzivni glet
Unutarnja masa za izravnavanje srednje opterećenih površina. Primjerena za vapnene, vapneno-cementne i cementne fine žbuke, gipskartonske ploče itd.

2

AKRIL Emulzija
Akrilni temeljni premaz Pogodno za sve vrste mineralnih podloga, primjeren i za gipskartonske ploče.




JUPOL Classic
Unutarnja zidna boja
Pogodno za manje opterećene zidne i stropne površine u stambenim i poslovnim objektima te drugim javnim objektima.

4


JUPOL Gold
Vrhunski pokrivna unutarnja periva boja Pogodno za sve jače opterećene unutarnje površine,na kojima je zahtijevan vrhunski estetski izgled.

Besplatno nijansiranje svih San marco unutarnjih boja i dekorativnih tehnika

CONCRET
ART INTER
Završna dekoracija sa izgledom betona za unutarnje i vanjske radove


Završna obrada za interijere koja omogućuje stvaranje površina s metalnim efektom (efekt četkanog metala).

Uz besprijekornu estetiku, Paeninsula pruža i vrhunske tehničke performanse, a to je visoka pokrivna moć, lakoća nanošenja i čišćenja.


Svaka nijansa pažljivo je kreirana za dizajnere interijera koji teže stvaranju prostora u skladu s najnovijim trendovima.
Paeninsula ULTRA MAT
Paeninsula BLAGI SJAJ
MARCOPOLO
Zidne šablone za dekoraciju
Dodajte osobni pečat prostoru uz naše višekratne, fleksibilne šablone za oslikavanje zidova – jednostavne za upotrebu s bojom po izboru.


cm





GEOMETRIC
58 x 90 cm
CIRCLE MANDALA
58 x 58 cm
58 x 90 cm
TRELLIS
58 x 90 cm
07 Zaštita na radu
Bačelić nudi širok asortiman certificirane zaštitne opreme za sigurnost na radu. U ponudi su kacige, rukavice, radna odjeća, obuća i oprema za rad na visini – sve prilagođeno profesionalnim potrebama i industrijskim standardima.


SOFTSHELL CITYCONIC
Antifon Magny Cours 2
zaštita sluha, sa školjkama od ABS-s
Najniža cijena u 30 dana: 20,23 €/kom
16,18 €/kom
bijela jakna
Najniža cijena u 30 dana: 75,60 €/kom 60,48 €/kom



Rastezljiva pamučna radna jakna ARDON CREATRON izrađena je od posebnog pamučnog materijala Amalytton, koji se ističe povećanom čvrstoćom i glatkom, mekom površinom.

Prsluk Activ Pro softshell bijelo sivi
65,20 €/kom
Najniža cijena u 30 dana: 81,50 €/kom

Jakna SOCCIA softshell tamnosiva/crna
39,61 €/kom
Najniža cijena u 30 dana: 49,51 €/kom

Jakna Horten2 softshell crna-narančasta
36,30 €/kom
Najniža cijena u 30 dana: 45,38 €/kom
Jakna softshell CREATRON crna
62,80 €/kom
Najniža cijena u 30 dana: 78,50 €/kom

Jakna softshell Allrounder bijelo-siva
47,92 €/kom
Najniža cijena u 30 dana: 59,90 €/kom

Jakna LULEA2 bijelo/siva
32,70 €/kom
Najniža cijena u 30 dana: 40,88 €/kom



KOMPLET ZA SPREČAVANJE PADA
ELARA 280 V2
+ Uprtač s 2 točke kopčanja (na leđima i na prsima)
+ 2 kopče za podešavanje veličine
+ 2 bočne kopče za podešavanje veličine
+ Apsorber energije s dvostrukim užetom (Y)
+ 1 spona AM018 i 2 hvataljke AM022
+ Uprtač za sprječavanje pada: remeni od poliestera
+ Uže s usporivačem pada: traka od poliestera
+ Karabiner kopča i kuka: čelik

Najniža cijena u 30 dana: 111,41 €/kom


Prsluk Stockton3 zimski radni prsluk s više džepova

Kišna jakna 850 plava
Najniža cijena u 30 dana: 35,08 €/kom
Najniža cijena u 30 dana: 19,53 €/kom

Cipela Pezzol Mustang S3
SRC, zaštitne cipele otporne na abraziju, sivo-crna
Najniža cijena u 30 dana: 80,00 €/kom
Cipela LEADER S3 visoka
Najniža cijena u 30 dana: 55,20 €/kom 55,20 €/kom

Dassy Kazan dvobojna flis jakna sa zatvaračem za zaštitu vrata
37,83 €/kom
Najniža cijena u 30 dana: 47,29 €/kom

Cipela Pezzol Emerson S3 SRC, poluvisoke zaštitne cipele otporne na abraziju
Najniža cijena u 30 dana: 84,00 €/kom

Čizma PVC Copper S5 zimske visoke radne čizme
Najniža cijena u 30 dana: 17,74 €/kom



Kupi Abarth. Osvoji poklon.
Uz kupnju bilo kojih Abarth cipela –poklon EXCESS čarape





Hlače Activ Pro Strech bijela/siva
cijena u 30 dana: 80,30 €/kom


Abarth 500
O2 SRC bijela

Hlače Superstrech bijela/siva
€/kom
cijena u 30 dana: 96,00 €/kom

Rukavica BATCH bijela
Najniža cijena u 30 dana: 3,30 €/kom 2,64 €/kom




Abarth Truck S1PL SR-FO sivoplava
Abarth
S3 SRC HRO siva
Cipela
Cipela
Cipela
595
Najniža cijena u 30 dana: 92,30 €/kom
Najniža cijena u 30 dana: 92,30 €/kom
Najniža cijena u 30 dana: 116,50 €/kom
Najniža
Najniža
COMBO SOFTFLEECE
vesta, bijela
34,08 €/kom


JEDNOKRATNA SKLOPIVA
MASKA M1300VBC FFP3
s kvalitetnom membranom za izdisanje
1,64 €/kom
Najniža cijena u 30 dana: 2,05 €/kom
Najniža cijena u 30 dana: 42,60 €/kom




Rukavica jednokratna
Diamond Nitrile crna, paket 50 kom
10,62 €/kom
Najniža cijena u 30 dana: 13,28 €/kom

Kaciga Baseball diamond V
građevinska kaciga od ABS-a, veća vidljivost u visinu, bijela fluo
14,53 €/kom
Najniža cijena u 30 dana: 18,16 €/kom
Rukavica Smart grip s premazom od nitrilne mikropjene
4,18 €/kom
Najniža cijena u 30 dana: 5,23 €/kom

Rukavica Hobby kožna
3,48 €/kom
Najniža cijena u 30 dana: 4,35 €/kom

Kaciga Granite wind
plava, od ABS-a s otvorima za prozračnost
29,98 €/kom
Najniža cijena u 30 dana: 37,48 €/kom

Naočale Hekla 2 Clear mogućnost nošenja preko dioptrijskih naočala
2,97 €/kom
Najniža cijena u 30 dana: 3,71 €/kom
Radionica
ID DEKORATIVNE TEHNIKE
Održana je još jedna odlična radionica u sklopu Bačelić akademije na kojoj smo zajedno upoznavali dekorativne tehnike branda ID.
Radili smo s ID Nacre – biserno baršunastim efektom, te s ID Sable d’Été – modernim i trenutno jako traženim efektom prirodnog pijeska koji unosi toplinu u prostor.
Od pripreme podloge, postupka nanošenja, isprobavali smo materijale i uvjerili se koliko zidovi mogu postati posebni.

Atmosfera je kao i uvijek bila kreativna i poticajna, a svi smo kući ponijeli nova znanja i puno inspiracije za uređenje interijera.




VEČER
DIZAJNERA INTERIJERA
Kukuljanovo Rijeka Srijeda 15.10.

od 17:30
Ponuda vrijedi od 1.10. do 31.10. ili do isteka zaliha. Fotografije su simbolične. Ne preuzimamo odgovornost za moguće tiskarske pogreške ili tehničke promjene. Naznačene cijene su maloprodajne s uključenim PDV-om. Akcija se ne zbraja s drugim popustima. Najniža cijena u zadnjih 30 dana vidljiva je na stranici bacelic.hr